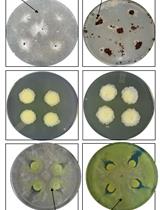
Bacteria-fungal Confrontation and Fungal Growth Prevention Assay

- Protocols
- Articles and Issues
- About
- Become a Reviewer
Past Issue in 2018
Volume: 8, Issue: 2
Biochemistry
Fish Bile Clean-up for Subsequent Zymography and Mass Spectrometry Proteomic Analyses
Cell Biology
Generation of Chemically Induced Liver Progenitors (CLiPs) from Rat Adult Hepatocytes
Measuring Mitochondrial ROS in Mammalian Cells with a Genetically Encoded Protein Sensor
Analysis of Exosome Transfer in Mammalian Cells by Fluorescence Recovery after Photobleaching
Microbiology
Multiple Stepwise Gene Knockout Using CRISPR/Cas9 in Escherichia coli
Detection of Protein Interactions in the Cytoplasm and Periplasm of Escherichia coli by Förster Resonance Energy Transfer
Identification and Quantification of Secondary Metabolites by LC-MS from Plant-associated Pseudomonas aurantiaca and Pseudomonas chlororaphis
Isolation and Purification of Viruses Infecting Cyanobacteria Using a Liquid Bioassay Approach
Bacteria-fungal Confrontation and Fungal Growth Prevention Assay
Infectious Subviral Particle to Membrane Penetration Active Particle (ISVP-to-ISVP*) Conversion Assay for Mammalian Orthoreovirus
Infectious Subviral Particle-induced Hemolysis Assay for Mammalian Orthoreovirus
Live-cell Imaging of Neisseria meningitidis Microcolony Dispersal Induced by Lactate or Other Molecules
Molecular Biology
Characterising Maturation of GFP and mCherry of Genomically Integrated Fusions in Saccharomyces cerevisiae
Neuroscience
Obtaining Acute Brain Slices
Common Carotid Arteries Occlusion Surgery in Adult Rats as a Model of Chronic Cerebral Hypoperfusion
Fluorescent Measurement of Synaptic Activity Using FM Dyes in Dissociated Hippocampal Cultured Neurons
Mechanical Allodynia Assessment in a Murine Neuropathic Pain Model
D-serine Measurements in Brain Slices or Other Tissue Explants
Plant Science
Determination of Boron Content Using a Simple and Rapid Miniaturized Curcumin Assay
Stem Cell
Mouse Satellite Cell Isolation and Transplantation
Human Endometrial Stem Cell Isolation from Endometrium and Menstrual Blood